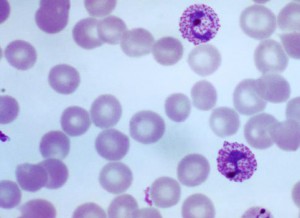

New on F1000Research – 18 May 2015
| 18 May, 2015 | Eva Amsen |
|

|
A selection of new content on F1000Research from the past week. To receive notification of all new articles, sign up for our table of contents alerts.
Featured article
Featured article
Adherence to Artemisinin Combination Therapy for the treatment of uncomplicated malaria in the Democratic Republic of the Congo [v2; ref status: indexed, https://f1000r.es/596]
M. Ruby Siddiqui, Andrew Willis, Karla Bil, Jatinder Singh, Eric Mukomena Sompwe, Cono Ariti
Malaria is on the rise in the Democratic Republic of the Congo. This article from MSF researchers identifies bad adherence to Artemisinin Combination Therapy as one of the causes of the rise in malaria in this region, and proposes educational programmes to ensure patients finish their treatment.
Other articles that recently passed peer review
Blockade or deletion of transient receptor potential vanilloid 4 (TRPV4) is not protective in a murine model of sepsis [v1; ref status: indexed, https://f1000r.es/57n]
Claire A. Sand, Anna Starr, Manasi Nandi, Andrew D. Grant
The “NF-ĸB interacting long noncoding RNA” (NKILA) transcript is antisense to cancer-associated gene PMEPA1 [v1; ref status: indexed, https://f1000r.es/5aq]
Johannes M. Dijkstra, David B. Alexander
Assessing the bipotency of in vitro-derived neuromesodermal progenitors [v1; ref status: indexed, https://f1000r.es/58z]
Anestis Tsakiridis, Valerie Wilson
To keep up with all new F1000Research articles, sign up for our table of contents alerts.

|

